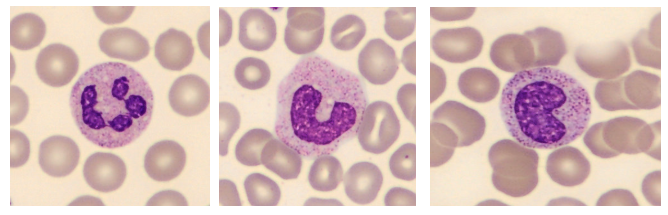

Alterações Laboratoriais na Leptospirose
A leptospirose é uma zoonose bacteriana de distribuição mundial que pode variar de quadros assintomáticos até formas graves, como a Síndrome de Weil. Embora muitas vezes apresente sintomas semelhantes aos de viroses comuns, a doença tem grande relevância em saúde pública devido à sua alta incidência, à letalidade elevada e às condições ambientais que favorecem sua transmissão. A infecção ocorre quando a pele ou as mucosas entram em contato com água ou solo contaminados pela urina de animais infectados, especialmente roedores, que atuam como principais reservatórios.
O gênero Leptospira reúne numerosos sorovares capazes de determinar diferentes manifestações clínicas, além de permanecerem no ambiente por longos períodos quando há umidade e pH adequados. Ademais, enchentes, períodos chuvosos e falhas no saneamento ampliam o risco de exposição humana. Diante desse cenário, compreender os aspectos epidemiológicos e laboratoriais da leptospirose é essencial para aprimorar o diagnóstico e orientar intervenções oportunas nas análises clínicas.
Alterações hematológicas na leptospirose
As alterações hematológicas refletem a resposta sistêmica à infecção e variam conforme a fase e a gravidade da doença. A anemia pode surgir nos casos mais graves, enquanto o leucograma se altera de maneira dinâmica. Nas fases iniciais, pode haver leucopenia; entretanto, quadros graves evoluem com leucocitose e neutrofilia. O desvio à esquerda indica resposta inflamatória intensa. A trombocitopenia também é frequente e ocorre devido ao consumo aumentado de plaquetas durante o processo infeccioso.
Alterações bioquímicas na leptospirose
As alterações bioquímicas refletem principalmente o comprometimento hepático, renal e muscular. O fígado geralmente apresenta disfunção funcional mais evidente do que dano estrutural, o que explica o padrão característico de enzimas hepáticas e bilirrubinas. O comprometimento renal é um dos achados mais relevantes, sobretudo nos casos graves, contribuindo para distúrbios hidroeletrolíticos e elevação de marcadores de função renal. Além disso, a mialgia acentuada e a resposta inflamatória podem gerar lesão muscular.
Principais alterações bioquímicas:
- Aumento moderado das transaminases, compatível com lesão hepática funcional.
- Elevação importante da bilirrubina, especialmente da fração direta, muitas vezes desproporcional às enzimas hepáticas.
- Elevação de ureia e creatinina, associada à disfunção renal e, em casos graves, à insuficiência renal aguda.
- Distúrbios eletrolíticos, como hipocalemia e hiponatremia.
- Aumento de CK decorrente da lesão muscular em quadros com mialgia intensa.
Alterações urinárias na leptospirose
As alterações urinárias refletem o tropismo das leptospiras pelos túbulos renais, já que esses microrganismos penetram e se multiplicam no tecido renal, comprometendo sua função. Como consequência, o sedimento urinário é profundamente alterado, sobretudo nos casos moderados e graves. O exame de urina torna-se um indicador precoce de lesão renal aguda, o que reforça sua importância no acompanhamento clínico.
Principais alterações urinárias:
- Proteinúria decorrente da inflamação tubular e da alteração da permeabilidade glomerular.
- Hematúria de intensidade variável devido ao dano renal.
- Piúria como resultado da inflamação dos túbulos renais.
- Cilindrúria, especialmente com cilindros granulosos e hemáticos, indicando lesão tubular.
- Alterações no volume urinário, já que quadros graves cursam com oligúria e menor capacidade de excreção.
- Presença inespecífica de bactérias no sedimento, refletindo inflamação ou contaminação secundária.
- Redução da densidade urinária devido à incapacidade dos túbulos lesionados de concentrar a urina.
Conclusão
A leptospirose permanece como um desafio significativo para a prática clínica e laboratorial, pois suas manifestações variam amplamente e podem simular outras doenças infecciosas. As alterações hematológicas, bioquímicas e urinárias desempenham papel fundamental no reconhecimento precoce da gravidade, já que refletem diretamente o impacto sistêmico da infecção, sobretudo sobre fígado e rins. Assim, a interpretação integrada desses achados permite antecipar complicações, orientar condutas terapêuticas e monitorar a evolução do paciente com maior precisão. Dessa forma, compreender os padrões laboratoriais característicos da leptospirose favorece o diagnóstico oportuno, contribui para a prevenção de desfechos graves e melhora a abordagem clínica em diferentes níveis de atenção à saúde.
Pós-Graduação em Bioquímica Clínica Avançada: Explore novos horizontes na sua carreira
Se você é um profissional dedicado na área da saúde em busca de aprimoramento e deseja desenvolver habilidades especializadas, senso crítico e expertise em Bioquímica Clínica, apresentamos a nossa Pós-Graduação como a escolha ideal para impulsionar sua carreira.
Desenvolvido para capacitar e atualizar profissionais como você, nosso programa altamente especializado oferece conhecimentos avançados que não apenas enriquecerão sua base de habilidades, mas também o destacarão no competitivo cenário profissional.
Oferecemos uma opção conveniente para quem busca uma pós-graduação 100% online e ao vivo, sem comprometer a excelência no ensino.
Nossa metodologia integra teoria e prática da rotina laboratorial, assegurando um aprendizado efetivo e aplicável.
Contamos com um corpo docente altamente qualificado, composto pelos melhores professores do Brasil, verdadeiras referências em suas respectivas áreas de atuação.
No Instituto Nacional de Medicina Laboratorial, nosso compromisso é singular: mais do que apenas transmitir conhecimento, buscamos transformar VOCÊ em uma referência.
Toque no botão abaixo e descubra mais sobre a Pós-Graduação em Bioquímica Clínica Avançada.
Sua jornada de excelência começa aqui.
QUERO CONHECER TODOS OS DETALHES DA PÓS-GRADUAÇÃO
Referências
ROCHA, Roberta Dias Rodrigues; OLIVEIRA, Breno Almeida de; MATIAS, Andressa Cristiane de Souza; MENDES, Cristina Lopes Zanette; PACHECO, Dayvid Henry de Carvalho; PEREIRA, Otávio Leoni Freitas; OLIVEIRA, Gleison de; FERREIRA, Ronize Andréia. Leptospirose ocupacional: da infecção aguda inespecífica à forma grave da síndrome de Weil – um relato de caso. Revista Ibero-Americana de Humanidades, Ciências e Educação – REASE, São Paulo, v. 1, n. 4, ed. esp., abr. 2025. ISSN 2675-3375.
PEQUENO, Aline Durão de Andrade; BILHEIRO, Camila Piola; FREITAS, Gabriel Alves; CAMILO, Giulia Simões Magalhães Peçanha; SOUZA, Larissa Toledo de Lima Duarte; PRADO, Leticia Simões; MORAIS, Mariana Silva de; AZIZI, Marco Antonio Alves (Prof.). Leptospirose. Acta MSM: Periódico da Escola de Medicina Souza Marques, v. 6, n. 2, 2018.
VIEIRA, António M.; BARROS, José; VALENTE, Cristina; TRINDADE, Luís; FARIA, M. João; FREITAS, Filomena. Leptospirose humana: breves considerações a propósito de uma casuística. Serviço de Doenças Infecciosas, Centro Hospitalar de Coimbra, Coimbra. Recebido para publicação em 30 nov. 1998.
SOUZA, Vânia Rodrigues de. Leptospirose: aspectos epidemiológicos, clínicos e laboratoriais. Governador Valadares, MG: Universidade Vale do Rio Doce – UNIVALE, julho 2011.



